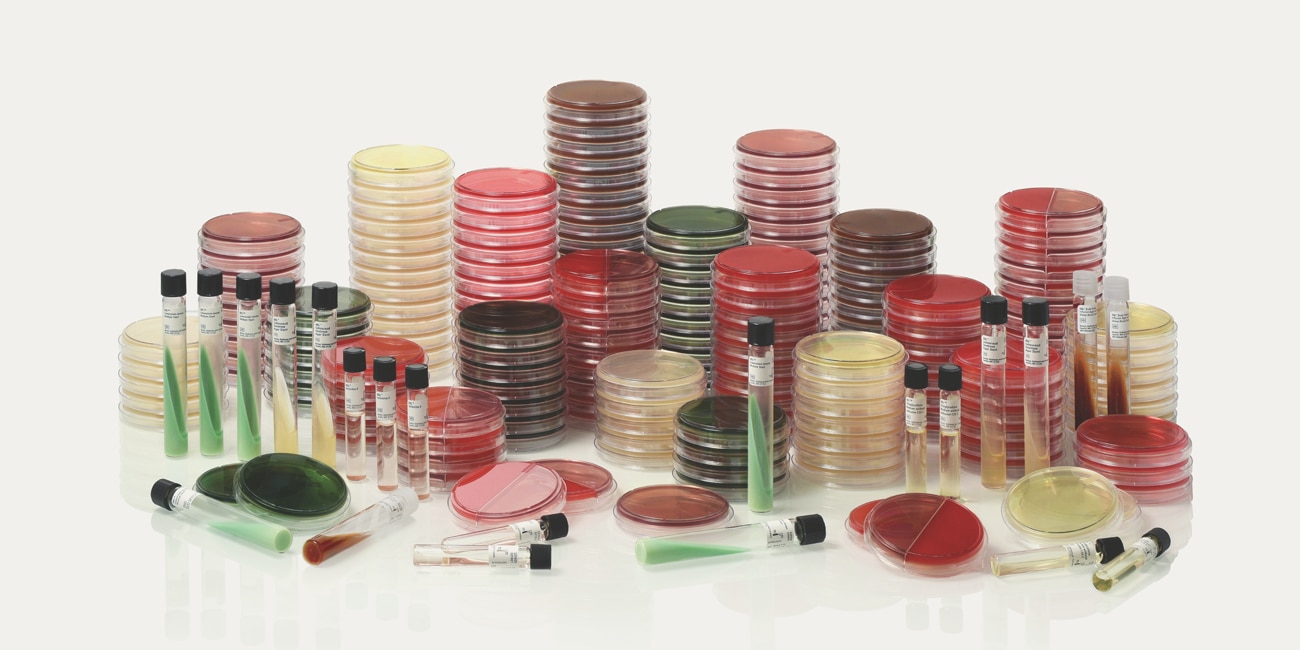

BD Isolator Cleanroom eXtended Temperature (IC-XT) plated media bieden de flexibiliteit en sample-integriteit die nodig zijn om te kunnen voldoen aan de hedendaagse behoeften op het gebied van omgevingsmonitoring. Dankzij de langere houdbaarheid en doordat ze kunnen worden bewaard bij kamertemperatuur (2-25 °C), leveren BD BBL™ IC-XT gebruiksklare plated media betrouwbare resultaten bij testen in kritische omgevingen.

- Overzicht
- eIFU en bronnen
BD Stacker™-schalen
De BD Stacker-schalen van 90 mm x 15 mm bevatten één mediumsamenstelling.
90 mm x 15 mm-stijl schalen met twee vakken
Deze schalen bestaan uit twee vakken die elk een andere mediumsamenstelling bevatten.
BD BBL™ CHROMagar™ -media
BD BBL™ CHROMagar™-media zijn geschikt voor incubatie, differentiatie of selectie van veel micro-organismen door gebruik te maken van chromogeensubstraten, en resulteren in kleurproductie. Deze kleuren onderscheiden zich, afhankelijk van het doel-micro-organisme, wat mogelijk zorgt voor een eenvoudiger en nauwkeurige differentiatie.
Houd er rekening mee dat mogelijk niet alle producten, diensten of kenmerken van producten en diensten beschikbaar zijn in uw regio. Neem contact op met uw plaatselijke BD-vertegenwoordiger.
De literatuurcollectie van BD over de industrie en over ons aanbod geeft u informatie die u kunt gebruiken om te blijven streven naar uitmuntendheid
BD biedt opleidingen aan om uw klinische werkwijzen te helpen verbeteren als onderdeel van ons doel om de wereld van de gezondheidszorg te verbeteren.
BD ondersteunt de gezondheidszorg met toonaangevende producten en diensten die de zorg verbeteren en de kosten verlagen. We organiseren en nemen deel aan evenementen die uitblinken in advancing the world of health™
BD promoot klinische uitmuntendheid door verschillende bronnen aan te bieden over best practices, klinische innovaties en industrietrends in de gezondheidszorg.
Houd er rekening mee dat mogelijk niet alle producten, diensten of kenmerken van producten en diensten beschikbaar zijn in uw regio. Neem contact op met uw plaatselijke BD-vertegenwoordiger.